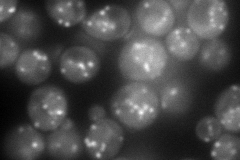
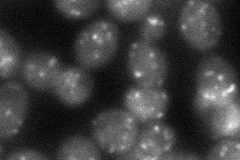
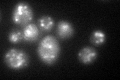

View description
Lanosterol synthase, an essential enzyme that catalyzes the cyclization of squalene 2,3-epoxide, a step in ergosterol biosynthesis
Localization:
Intensity:
Fold change:
Significance:
-
C’ GFP library in SD

punctate31.97 -
N' NOP1pr-GFP in SD
punctate136.762 -
N' TEF2pr-mCherry in SD

punctate144.412 -
N' NATIVEpr-GFP in SD

punctate20.8593 -
N' TEF2pr-VC and Cyto-VN in SD
punctate50.4579 -
C’ GFP library in SD+DTT
punctate31.60.98No -
C’ GFP library in SD+H2O2

punctate27.90.87No -
C’ GFP library in Starvation Media

punctate39.221.22No -
C’ GFP library on the background of Pup2-DaMP

punctate -
C’ GFP library on the background of CCT mutant

punctate27.36090.855563No
